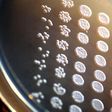
The team first studied autophagy in an engineered version of a simple  budding yeast called Saccharomyces cerevisiae, a fungus that is central to  the fermentation needed for winemaking and beer brewing.

Author
sQuashie
Stay tuned! This author's bio is coming soon - check back soon to learn more about the person behind the stories!
Pulse Ghana
15.11.2016
Advertisement
Advertisement
)

)
)
)
)
)
)
)
)
)
)
)
)
)
)
)
)
)
)